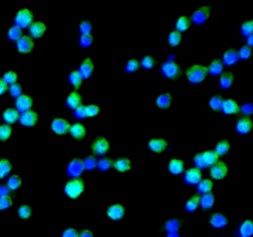

| Synonyms: | Adhesion G protein-coupled receptor E1|EGF-like module receptor 1|EGF-like module-containing mucin-like hormone receptor-like 1|EMR1 hormone receptor|ADGRE1|EMR1|TM7LN3|F4/80 antibody | ||
| Catalogue No.: | FNab02922 | Reactivity: | Human, Mouse, Rat |
| Host: | Rabbit | Tested Application: | ELISA, WB, IHC, IF |
| Clonality: | polyclonal | Isotype: | IgG |
| Size | |
|---|---|
| 100µg | Inquiry |
Dispatch Time: About 3 working days
- Product Name
- ADGRE1 antibody
- Catalogue No.
- FNab02922
- Size
- 100μg
- Form
- liquid
- Purification
- Immunogen affinity purified
- Purity
- ≥95% as determined by SDS-PAGE
- Clonality
- polyclonal
- Isotype
- IgG
- Storage
- PBS with 0.02% sodium azide and 50% glycerol pH 7.3, -20℃ for 12 months(Avoid repeated freeze / thaw cycles.)
Immunogen
- Immunogen
- EGF-like module containing, mucin-like, hormone receptor-like sequence 1
- Alternative Names
- Adhesion G protein-coupled receptor E1|EGF-like module receptor 1|EGF-like module-containing mucin-like hormone receptor-like 1|EMR1 hormone receptor|ADGRE1|EMR1|TM7LN3|F4/80 antibody
- UniProt ID
- Q14246
- Observed MW
- 160 kDa
Application
- Tested Applications
- ELISA, WB, IHC, IF
- Recommended dilution
- WB: 1:500-1:1000; IHC: 1:20-1:200; IF: 1:50-1:500
Validated Images
 HL-60 cells were subjected to SDS PAGE followed by western blot with FNab02922(F4/80 Antibody) at dilution of 1:1000
HL-60 cells were subjected to SDS PAGE followed by western blot with FNab02922(F4/80 Antibody) at dilution of 1:1000  Immunohistochemistry of paraffin-embedded mouse spleen tissue slide using FNab02922(F4/80 Antibody) at dilution of 1:200
Immunohistochemistry of paraffin-embedded mouse spleen tissue slide using FNab02922(F4/80 Antibody) at dilution of 1:200 Immunofluorescent analysis of ( 10% Formaldehyde ) fixed Raw264.7 cells using FNab02922 (F4/80 antibody) at dilution of 1:50 and FITC-conjugated Goat Anti-Rabbit IgG(H+L)
Immunofluorescent analysis of ( 10% Formaldehyde ) fixed Raw264.7 cells using FNab02922 (F4/80 antibody) at dilution of 1:50 and FITC-conjugated Goat Anti-Rabbit IgG(H+L) IF: 14.907
- Journal:
- Acta Pharmaceutica Sinica B
- Author:
- Institute of Hematology, Union Hospital, Tongji Medical College, Huazhong University of Science & Technology, Wuhan 430022, China
- Cited Date:
- 2023-06-23
- Product:
IF: 8.2
- Journal:
- Cell Communication and Signaling
- Author:
- Department of Otorhinolaryngology Head and Neck Surgery, The Third Xiangya Hospital, Central South University, Changsha, Hunan, China.
- Sample:
- THP-1 monocytes
- Cited Date:
- 2024-09-06
- Product:
- Journal:
- Iraqi Journal of Veterinary Sciences
- Cited Date:
- 2022-01-07
- Product:



